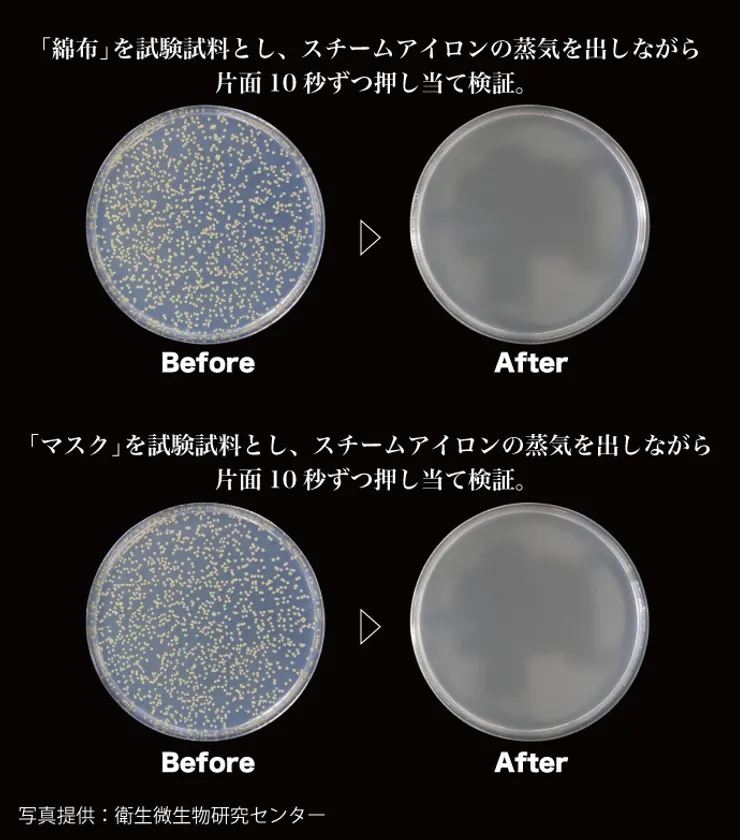

衣類スチーマーで除菌ができる!? 「99.9%除菌でマスクの再利用も可能」
株式会社LESTAR(本社:東京都港区、代表取締役:平賀 一起、以下 LESTAR)は、衣類スチーマーの新しい活用方法をご提案します。
製品URL: https://www.makuake.com/project/kalos_beauty/

商品イメージ1
■衣類スチーマー(Rooomy)
株式会社KALOS BEAUTY TECHNOLOGYが製造/開発するスタイリッシュスチーマーは業界最大級のスチーム量(※1)を誇り、衣類のシワ伸ばしのほか、除菌(※2)・花粉対策(※3)・ダニ対策(※4)・タバコ臭(※5)・飲食臭(※6)・汗臭(※7)・防虫剤臭(※8)にも一定の効果があることが日本国内の第三者機関の調査によりわかりました。
■除菌試験(※2)
50mm×50mmに切断した綿布と30mm×25mmに切断した市販のマスクを試験試料とし、試験菌液をそれぞれに接種。接種後、試験試料を30分間風乾させ効果を検証。
その結果、菌が検出されることはありませんでした。

商品イメージ2
検証(1)

検証(2)
■検証実績
※1 チーム量は使用環境によって異なります。強モード:約25g/分 弱モード:約18g/分(スチーム量は当社調べ)
※2 試験機関:株式会社衛生微生物研究センター 試験報告書番号:2020D-BT-154 試験方法:50mm×50mmに切断した綿布と30mm×25mmに切断した市販のマスクを試験試料とし、試験菌液を綿布には0.1mL、マスクには0.05mL接種。その後、検体に滅菌水を入れて電源を入れ、蒸気出しながら試験試料に片面10秒間ずつ、合計20秒間押し当てた。 検査結果:菌が検出されなかった。
※3 試験機関:ITEA株式会社東京環境アレルギー研究所 試験報告書番号:T2003039 試験方法:アイロン台の上に高密度綿布を乗せ、ベースシート上の散布領域内にスギ花粉を散布し、その上にさらに綿布を被せた。被せたカバーシートの上から、散布領域内にスチームが当たるよう被験物を動かし測定。 検査結果:アレルゲン低減率77.5%
※4 試験機関:ITEA株式会社東京環境アレルギー研究所 試験報告書番号:T2003039 試験方法:生きたダニを50匹以上乗せた試験片にスチームを噴霧しながら10秒間検体を当てた。 検査結果:死ダニ率100%
※5 試験機関:一般財団法人日本食品分析センター 試験報告書番号:20036399 試験方法:タバコ臭のする布(ウール100%)にスチームを噴射しながら片面10秒間ずつ、合計20秒間検体を当て、パネリスト12名で採点法による官能評価を行った。 検査結果:タバコ臭は軽減された。
※6 試験機関:一般財団法人日本食品分析センター 試験報告書番号:20036399 試験方法:飲食臭のする布(ウール100%)にスチームを噴射しながら片面10秒間ずつ、合計20秒間検体を当て、パネリスト12名で採点法による官能評価を行った。 検査結果:飲食臭は軽減された。
※7 試験機関:一般財団法人日本食品分析センター 試験報告書番号:20036399 試験方法:汗臭のする布(ウール100%)にスチームを噴射しながら片面10秒間ずつ、合計20秒間検体を当て、パネリスト12名で採点法による官能評価を行った。 検査結果:汗臭は軽減された。
※8 試験機関:一般財団法人日本食品分析センター 試験報告書番号:20036399 試験方法:防臭剤臭のする布(ウール100%)にスチームを噴射しながら片面10秒間ずつ、合計20秒間検体を当て、パネリスト12名で採点法による官能評価を行った。 検査結果:防臭剤臭は軽減された。
【商品概要】
カラー :ホワイト / ピンク / グリーン
電源 :100V 50/60Hz
消費電力 :1000w
本体サイズ :約152×76×232mm
本体重量 :約700g
水タンク容量 :140ml
スチーム気量 :18g/分-弱 25g/分-強
スチーム持続時間:10分-弱 7分-強
プレート温度 :110~130℃
スチーム温度 :≧100℃
コード長さ :約1.9m
【会社概要】
商号 : 株式会社LESTAR
代表者: 代表取締役 平賀 一起
所在地: 東京都港区港南1-8-23 1814
設立 : 2019年4月
URL : https://www.lestar.jp/
















